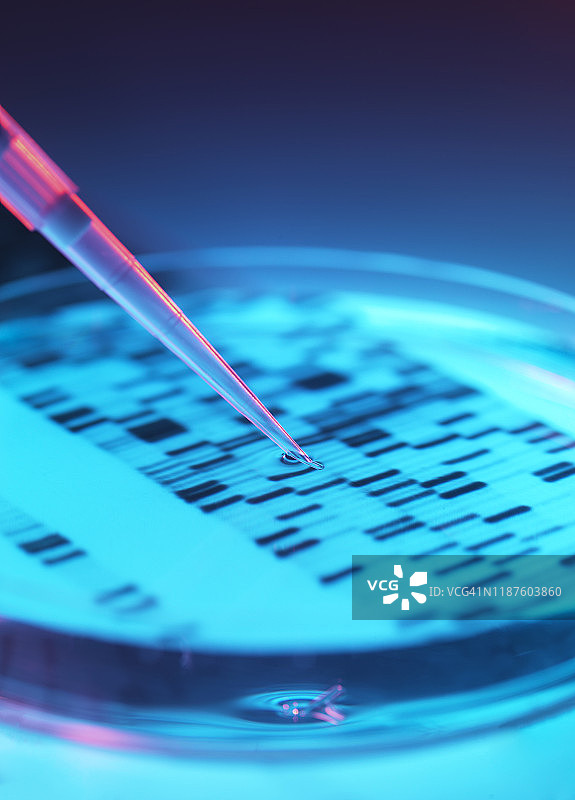

图片
- 图片
- 视频
- 音频
- 字体
DNA研究,用DNA自显影照片移液到培养皿中
DNA研究,用DNA自显影照片移液到培养皿中图片素材作品是由视觉中国旗下网站(VCG.COM)的图片品牌合作方:Cavan提供,作品作者是:Cavan Images/视觉中国;图片ID:VCG41N1187603860;最大规格:4022 x 5600 px (300ppi) | TIFF 64.44 MB;存储大小:9.14 MB - JPG;授权方式是:;当前图片素材提供下载与正版授权服务,助力您的品牌提升。
图片ID:VCG41N1187603860
作者/来源: Cavan Images/Getty Creative
品牌:Cavan
最大尺寸:4022 x 5600 px (300ppi) | TIFF 64.44 MB | 34.05 x 47.41 cm (13.41 x 18.67 in.)
存储大小:9.14 MB - JPG
购买咨询
